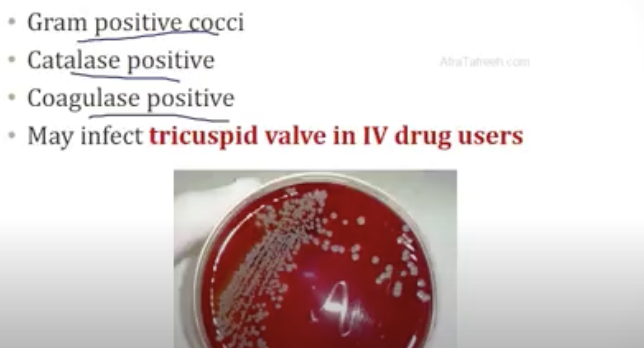

what is endocarditis?

what are the general symptoms found in endocarditis?

what are the embolic symptoms seen in endocarditis?

what are the endocarditis stigmata?
physical exam findings found in endocarditis caused by septic emboli + immune complexes

how do you diagnose endocarditis?

what are the causative organisms in endocarditis?

staph aureus:
microbe features
which type of endocarditis?
typical patient?
how severe is staph aureus endocarditis?
which type of valve affected?

viridans streptococcus:
microbe features
which type of endocarditis?
typical patient?

how severe is viridans streptococcus endocarditis?

which type of valve affected in viridans streptococcus endocarditis?

strep bovis:
microbe features
which type of endocarditis?
typical patient?

enterococcus:
microbe features
which type of endocarditis?
typical patient?

what is prostethic valve endocarditits?
cause?
treatment?

staph epidermidis:
microbe features
which type of endocarditis?
typical patient?

what is culture negative endocarditis?

what is coxiella Burnetti?
what does it cause?

what is Q fever?

what is bartonella?

what is non-bacterial thrombotic endocarditis (NBTE)?
what valve affected?
who affected?

symptoms in NBTE?

how do you tx bacterial endocarditis?

what are complications of bacterial endocarditis?

who gets prophylaxis for endocarditis?




